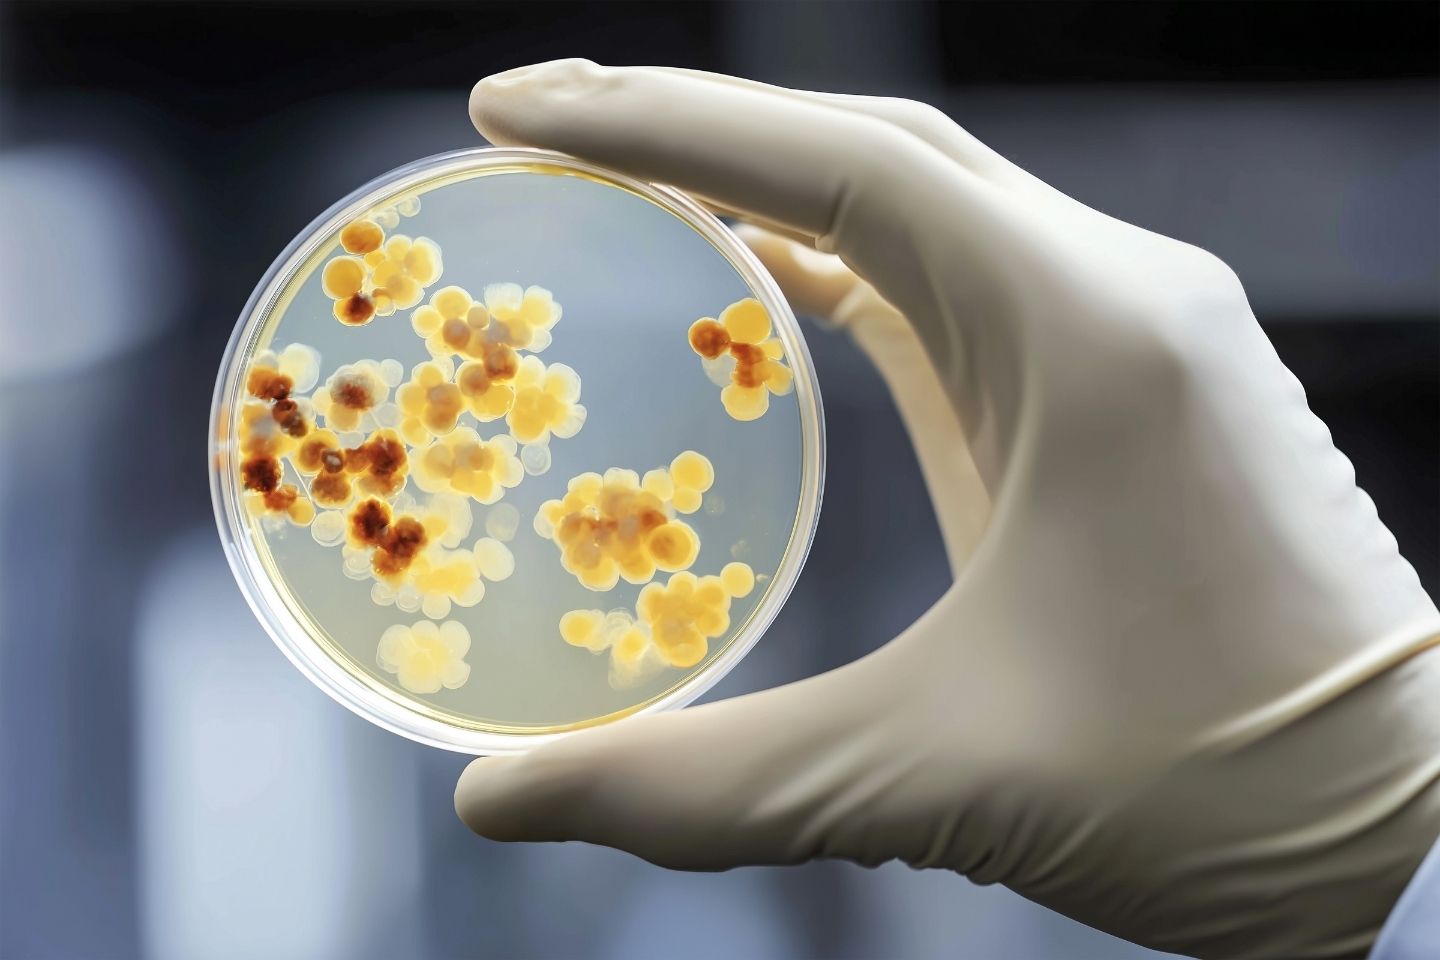
Petrijeva zdjelica s kolonijama kvasnice Candida auris

Kandidijaza – uzroci, simptomi, vrste i liječenje
Kandidijaza je gljivična infekcija koju uzrokuje prekomjeran rast nekih vrsta Candida, najčešće Candida albicans. Može zahvatiti kožu, sluznice i unutarnje organe, a najčešći simptomi su svrbež, crvenilo, peckanje i bijele naslage.
Što je kandidijaza?
Kandidijaza je gljivična infekcija koju uzrokuje prekomjeran rast kandide (Candida), vrste kvasca koji živi u našem tijelu. S obzirom da se radi o vrlo raznolikom rodu kvasaca, najčešće se misli na Candidu albicans.
Candida albicans je inače komenzal* koji je sastavni dio fiziološke flore na sluznicama zdravog organizma, tako da je nalazimo na:
- sluznici rodnice (35 posto zdravih žena)
- u gornjem dijelu dišnog sustava – u usnoj šupljini i ždrijelu (77 posto zdravih osoba)
- u probavnom sustavu (85 posto osoba).
Kandidu nalazimo i u normalnoj flori usne šupljine već u novorođenčeta starog nekoliko dana. Stoga ne čudi da antitijela protiv kandide ima gotovo 85 posto stanovništva.
* Komenzalizam - oblik simbioze, tj. zajedničkog života dviju različitih vrsta u kojem jedan organizam (komenzal) ima korist, dok drugi (domaćin) nema nikakvu štetu ni korist.
Kandida ponekad može nekontrolirano rasti, uzrokujući širok raspon simptoma. Može oštetiti crijevnu stijenku, što dovodi do pojave sindrom propusnog crijeva, i može poremetiti probavu.
Candida albicans kao patogen u crijevima oslobađa do 79 različitih metabolita, uključujući mokraćnu kiselinu, amonijak i acetaldehid.
Acetaldehid uzrokuje kronične glavobolje i maglu u mozgu, a Međunarodna agencija za istraživanje raka klasificira ga kao potencijalni kancerogen.
Mokraćna kiselina može uzrokovati bolove u zglobovima i dovesti do gihta ako se nakupi u suvišku.
Pojavnost kandidijaze češća je u žena nego kod muškaraca i češće se javlja u toplijim mjesecima.
Kandida je obično neškodljiva i zdrave osobe rijetko obolijevaju od bolesti uzrokovanih ovim kvascem.
Iako se općenito kandidijaza može liječiti antifungalnim lijekovima, neke vrste mogu biti teške za liječenje. Na primjer, Candida auris je gljivična vrsta otporna na više lijekova i odgovorna za izbijanja bolesti u bolnicama i ustanovama za dugotrajnu njegu.
Prevencija i pravilno liječenje ključni su za smanjenje rizika i širenja ovih infekcija.
Vrste Candide
Candida je najčešća gljivica koja inficira ljude.
Iako je poznato više od 150 različitih vrsta pripadnika roda Candida, samo je nekoliko njih važno za pojavu upalnih bolesti kod ljudi.
U devet od deset slučajeva kandidijaze uzrok je jedna od ovih pet vrsta:
- Candida albicans
- Candida glabrata
- Candida tropicalis
- Candida parapsilosis
- Candida krusei.
Infekcije s drugim vrstama su u porastu i liječnicima može biti teže liječiti ih.
Osim pet navedenih vrsta, stručnjaci prate i Candidu auris, koja predstavlja sve veću zdravstvenu prijetnju.
Candida albicans - daleko najčešći uzrok infekcije
Jednostanična gljiva Candida albicans (rod Candida, porodica gljiva kvasnica Saccharomycetaceae) je daleko najčešća i uzrokuje više od polovice svih infekcija kandidom.
Parazitski oblik kandide u organizmu izlučuje otpadne tvari koje opterećuju jetru i cijelo tijelo. Tako, primjerice, kandida može proizvesti vrstu lažnog estrogena koji tijelu signalizira da ga ima dovoljno, što narušava njegovu prirodnu sintezu i može dovesti do poremećaja menstruacijskog ciklusa.
Ako joj je pristupačan šećer, gljivica može proizvesti etanol i acetaldehid, koji se zamjećuje u neugodnom zadahu iz usta, a može prouzročiti i probleme s koncentracijom, izazvati kronični umor, česte glavobolje, psihičku nestabilnost, promjene raspoloženja te izraženiji PMS.
Je li Candida albicans zarazna?
Gljivične infekcije obično nisu zarazne.
Candida albicans se može proširiti ako osoba ima oslabljen imunosni sustav ili uzima određene lijekove.
Ako je osoba zdrava, malo je vjerojatno da će doći do njezina umnažanja i širenja.
Uzroci kandidijaze
U normalnim okolnostima, dobre bakterije sprječavaju prekomjeran rast kandide.
Do pojačana rasta i umnožavanja kandide dolazi zbog djelovanja različitih čimbenika koji nepovoljno utječu na ravnotežu fiziološke flore i imunost općenito zbog čega kažemo da je kandida uvjetno patogeni mikroorganizam.
Do poremećaja ravnoteže zdravih bakterija i kandide mogu dovesti:
- određena medicinska stanja, uključujući rak, dijabetes i HIV/AIDS
- stres
- nezdrave prehrambene navike - konzumiranje hrane bogate rafiniranim ugljikohidratima, šećerom ili kvascem
- stanja oslabljene imunosti (kronične endokrinološke, onkološke i imunodeficitarne bolesti, transplantacija...)
- hormonalne promjene – promjene unutar menstruacijskog ciklusa, trudnoća, menopauza
- uzimanje određenih lijekova, uključujući antibiotike, oralne kontraceptive, kortikosteroide, psihotropne lijekove
- češća promjena partnera.
Kao posljedica prekomjerna rasta kandide dolazi do pojave simptoma poput nelagode, svrbeža i iritacije.
Kandidijazu treba odmah liječiti kako bi se ublažili simptomi. Ako se teška infekcija ne liječi, može se proširiti na druge dijelove tijela, uključujući krv, srce i mozak.
Simptomi kandidijaze
Ovisno o području u kojem je nastalo prekomjerno razmnožavanje kandide, mogu se javiti različiti simptomi:
- snažna želja za slatkom hranom, kruhom, tjesteninom
- neugodan zadah iz usta
- bijele mrlje ili rane u ustima i grlu
- gubitak okusa (ageuzija)
- otežano gutanje (disfagija)
- nadutost tijekom i poslije jela
- vjetrovi
- osjećaj sitosti
- infekcije i upale
- česte prehlade
- alergija ili preosjetljivost
- suha sluznica
- suha koža
- osip na koži s malim, izdignutim kvržicama
- poremećena razina šećera u krvi
- hladne ruke i stopala
- hemoroidi
- proljev ili zatvor
- vaginalna infekcija i/ili bol, svrbež i pojačan vaginalni iscjedak specifična izgleda i mirisa...
Mnoge osobe koje razviju invazivnu kandidijazu već su bolesne, stoga može biti teško utvrditi koji su simptomi posljedica izvornog stanja, a koji posljedica infekcije. No, kako se infekcija širi po tijelu, dolazi do razvoja zimice i vrućice.
Karakteristike i simptomi kandidijaze razlikuju se ovisno o vrsti i mjestu infekcije.
Vrste kandidijaze prema mjestu infekcije
Budući da kvasci prirodno žive na našem tijelu, postoje različite vrste kandidijaze ovisno o mjestu infekcije, a to su:
- kandidijaza mokraćnog sustava
- genitalna kandidijaza
- kandidijaza probavnog sustava
- kožna kandidijaza (dermatomikoza)
- sistemska kandidijaza
- novorođenačka kandidijaza.

Kandidijaza mokraćnog sustava
Vrsta Candida najčešći je uzrok gljivičnih infekcija mokraćnog sustava.
Mokraćne infekcije uzrokovane kandidom mogu se pojaviti u donjem dijelu mokraćnog sustava ili se, u nekim slučajevima, mogu popeti do bubrega.
Rizični čimbenici za pojavu kandidijaze mokraćnog mjehura su::
- uzimanje antibiotika
- ugradnja medicinskog uređaja, poput urinarnog katetera
- dijabetes
- oslabljen imunosni sustav.
Simptomi kandidijaze mokraćnog sustava
Mnoge osobe s mokraćnom infekcijom uzrokovanom kandidom nemaju simptoma.
Ako su simptomi prisutni, mogu uključivati:
- povećanu potrebu za mokrenjem
- bolnost ili peckanje pri mokrenju
- bol u trbuhu ili zdjelici
- krv u mokraći.
Genitalna kandidijaza
Kad govorimo o ženama, vaginalna kandidijaza najčešći je oblik kandida infekcije. Tome u prilog govore procjene da se javlja kod 75 posto seksualno aktivnih žena barem jednom u životu, da polovica njih ima više od jedne infekcije, a gotovo 10 posto često ponavljajuće upale.
S obzirom da je vaginalna kandidijaza tako učestala, potrebno je znati razliku između gljivične i bakterijske vaginalne infekcije.
Žene češće obolijevaju od vaginalne kandidijaze između puberteta i menopauze jer pod utjecajem hormona estrogena, stanice koje oblažu vaginu proizvode šećer. Kvasnice se hrane tim šećerima. Stoga je kandidijaza rijetka prije puberteta, kod dojilja (koje imaju nisku razinu estrogena u cirkulaciji) i nakon menopauze (osim ako žena ne uzima menopauzalnu hormonsku terapiju ili ima dijabetes).
Kiselost rodnice i drugi normalno prisutni mikroorganizmi održavaju broj kandide na sluznici rodnice malenim. Izvor infekcije najčešće je vlastita kandida, koja se pod određenim okolnostima umnožava i dovodi do razvoja upale.
Uzrok lokalnim promjenama je smanjenje kiselosti rodnice i broja neškodljivih mikroorganizama.
Do smanjenja kiselosti rodnice obično dovode menstruacija, trudnoća, menopauza, šećerna bolest, hormonska kontracepcija s estrogenom, kortikosteroidi i neki antibiotici, ali i prisutnost sperme koja je alkalna (lužnata).
Ostali razlozi koji remete normalnu ravnotežu i pogoduju infekciji su pretjerana konzumacija alkohola, nošenje uske odjeće i sintetičkog donjeg rublja te pranje spolovila neodgovarajućim sredstvima.
U određenim patološkim stanjima, kandida može uzrokovati teške infekcije, koje su utoliko teže što je teži osnovni poremećaj. Tako razvoj kandidijaze pospješuju šećerna bolest, smanjena funkcija nekih žlijezda (štitnjače, doštitnih žlijezda, nadbubrežne žlijezde), karcinom, smanjena sinteza imunoglobulina, SIDA itd.
I liječenje antibioticima može poremetiti fiziološku floru na sluznicama, što posljedično izaziva prerastanje kandide i razvoj upale.

Simptomi vaginalne kandidijaze
Vaginalna kandidijaza očituje se neugodnim svrbežom spolovila uz pojavu pojačanog vaginalnog iscjetka koji je bjelkaste boje, sirast i specifična mirisa po ribi.
Sluznica rodnice i stidnice je crvena, natečena i bolna, zbog čega i spolni odnos može biti bolan (dispareunija).
Tijekom mokrenja često se javlja osjećaj peckanja i žarenja jer mokraća nadražuje oštećenu površinu stidnice.
Nastojanje da se svrbež ublaži samo pogoršava simptome.
Kandidijaza u trudnoći
Zašto je kandidijaza česta u trudnoći? – Kandidijaza pogađa oko 30 posto trudnica i to zbog povišene razine estrogena i glikogena koji mijenjaju pH rodnice i potiču prekomjerni rast Candide..
Je li kandidijaza opasna u trudnoći? – Kandidijaza je prilično bezopasna za fetus. No, ako se ne liječi ili se radi o teškoj ili ponavljajućoj infekciji, može povećati rizik od prijevremenog pucanja vodenjaka, prijevremenog poroda ili kongenitalne kožne kandidijaze.
Kako se liječi kandidijaza u trudnoći? – Lokalno se primjenjuju antifungalni lijekovi. Terapiju treba provoditi samo prema preporuci liječnika. Oralni antimikotici se izbjegavaju.
Uvijek se posavjetujte s ginekologom ili liječnikom za dijagnozu i liječenje kandidijaze tijekom trudnoće.
Candida može zaraziti i muške genitalije, što ne treba čuditi ako znamo da je normalno prisutna na koži.
Međutim, gljivične infekcije muškoga spolnog sustava daleko su rjeđe nego kod žena.
Muškarci imaju veću vjerojatnost razvoja kandidijaze na glaviću penisa ako:
- imaju spolne odnose s partnericom koja ima ponavljajuću vaginalnu kandidijazu - kod oko 15 posto muškaraca nakon samo jednog spolnog odnosa sa ženom koja ima razvijenu infekciju mogu se pojaviti simptomi balanopostitisa unatoč činjenici što njihove partnerice nemaju izraženijih simptoma. Osim standardnih simptoma kandidijaze, nema drugih komplikacija.
- nisu obrezani
- često uzimaju antibiotike
- imaju dijabetes
- imaju oslabljen imunosni sustav
- imaju prekomjernu težinu
- ne peru se redovito.
Simptomi balanopostitisa kod muškaraca uključuju:
- vlažnu kožu na penisu
- bjelkastu tvar u naborima kože
- osip spolovila
- nelagodu
- crvenilo, svrbež ili peckanje.
U većini slučajeva infekcija se očituje crvenilom, peckanjem, svrbežom, osipom spolovila i nelagodom, ali bez drugih komplikacija.
Kožna kandidijaza (dermatomikoza)
Pripadnici roda Candida jedan su od mogućih uzročnika i kožne kandidijaze, odnosno dermatomikoze.
Najčešće se javlja na područjima kože koja se međusobno taru (područje pregiba velikih zglobova - pazuh, lakat, koljeno, prepone; ispod dojki; kod gojaznih osoba na trbušnim pregibima itd.).
Moguća lokalizacija je i među prstima na rukama i nogama, na noktima i okolnom tkivu, što zovemo onihomikoza.
Stanja koja povećavaju vjerojatnost kožne kandidijaze uključuju:
- vruće ili vlažno vrijeme
- nošenje uskog ili sintetičkog donjeg rublja ili odjeće
- nedovoljno pranje
- nedovoljno često mijenjanje donjeg rublja ili pelena (pelenski osip od gljivične infekcije – koža crvena i osjetljiva uz podignuti crveni rub oko ranica)
- slab imunosni sustav
- trudnoća
- prekomjerna težina
- uzimanje antibiotika ili drugih lijekova
- druga kožna stanja, poput psorijaze.
Simptomi kožne kandidijaze
Kožna kandidijaza uzrokuje pojavu crvenih i vlažnih mrlja na koži, s malim izdignutim kvržicama, crvenilo kože i izražen svrbež.
Kandidijaza probavnog sustava
Dijagnozu kandidijaze probavnog sustava teško je postaviti jer je kandida inače normalan stanovnik usne šupljine i probavnog sustava, tako da pozitivan nalaz iz stolice ne mora značiti i invazivnu infekciju.
Ako pod određenim uvjetima ipak dođe do prekomjerna umnažanja kandide, može se razviti:
- oralna kandidijaza
- kandidijaza jednjaka
- crijevna kandidijaza.
Simptomi oralne kandidijaze
Oralna kandidijaza se očituje bezbolnim bjelkastim promjenama na sluznici usne šupljine.
Kod nekih osoba može se pojaviti crvenilo i bolnost.
Pri pokušaju struganja, ispod mrlje nalazi se crveno, upaljeno područje koje, posebno na jeziku i nepcu te oko usana, može lagano krvariti.
U kutovima usana mogu se pojaviti ispucala, crvena, vlažna područja kože. Mrlje nisu bolne, samo ponekad.
Može se pojaviti i gubitak okusa (ageuzija).

Simptomi kandidijaze jednjaka
Candida ezofagitis može uzrokovati otežano gutanje (disfagija) ili bolno gutanje, kao i bol u prsima iza prsne kosti (sternuma).
Kako ti simptomi upućuju i na neke druge, ozbiljnije bolesti, obvezno se treba javiti liječniku
Simptomi crijevne kandidijaze
U slučaju umnožavanja kandide u crijevima, javlja se proljev, s tim da je ova varijanta teško dokaziva.
Sistemska kandidijaza
Sistemska kandidijaza nastaje kad kandida prodre u krvni optok. Candida je odgovorna za oko 80 posto svih sistemskih gljivičnih infekcija.
Sistemske gljivične bolesti razvija oko 15 posto osoba s oslabljenim imunosnim sustavom.
U imunokompromitiranih osoba infekcija kandidom može zahvatiti jednjak i druge dijelove probavnog sustava te se širiti krvlju te nastaje kandidemija – ozbiljna infekcija krvotoka. Ako se odmah ne liječi, često je smrtonosna.
Po život opasna forma sistemske infekcije kandidom je tzv. invazivna kandidijaza, koja se širi u različite dijelove tijela organe, tako da je moguć razvoj gljivične upala različitih organa kao što su srčani zalisci, mozak, slezena, bubrezi i oči.
Ključan čimbenik razvoja invazivne kandidijaze je neutropenija, odnosno drastično smanjen broj bijelih krvnih stanica neutrofila, što povećava sklonost infekcijama i može dovesti do razvoja različitih scenarija, kao što su:
- endokarditis - infekcija unutarnje ovojnice srca, koja uključuje srčane komore i zaliske
- endoftalmitis - upala oka koja može dovesti do gubitka vida
- meningitis - upala moždanih ovojnica koje obavijaju mozak i leđnu moždinu. Gljivični meningitis uzrokovan Candidom često se dobiva u bolnici.
- intraabdominalna kandidijaza ili Candida peritonitis - upala potrbušnice
- osteomijelitis - infekcija kostiju
- gljivični artritis ili septički artritis - gljivična infekcija zgloba.
Osobe pod rizikom razvoja sistemske kandidijaze su:
- novorođenčad male porođajne težine
- kirurški pacijenti
- hospitalizirani pacijenti
- pacijenti s centralnim venskim kateterom
- osobe s jako oslabljenim imunosnim sustavom (SIDA, onkološki bolesnici – primjena citostatika, kemoterapija, osobe na transplantaciji)
- osobe koje već boluju od dijabetesa, zatajenja bubrega ili uzimaju jake antibiotike.
Može biti teško dijagnosticirati sistemsku kandidijazu jer je vjerojatno da je osoba s ovom infekcijom već bolesna od nekog drugog stanja.
Sistemska infekcija dijagnosticira se dokazom uzročnika u kulturi krvi i zaraženom tkivu.
Neke vrste Candide, uključujući Candida auris, razvijaju otpornost na antifungalne lijekove, što otežava njihovo iskorjenjivanje s bolničkih površina i opreme. Ove infekcije su ozbiljne i zahtijevaju hitnu intravensku antifungalnu terapiju.
Ako infekcija ne odgovara na liječenje, može uslijediti smrt.
Simptomi sistemske kandidijaze
Sistemska kandidijaza može uzrokovati širok raspon simptoma, od neobjašnjive zimice i vrućice koje se ne povlače na antibiotsku terapiju do šoka i zatajenja više organa.
Mnoge osobe kod kojih se razvije invazivna kandidijaza već su bolesne. Stoga može biti teško utvrditi koji su simptomi posljedica izvornog stanja, a koji su posljedica infekcije.
Ako dođe do širenja infekcije na duboke organe (bubrezi, jetra, kosti, mišići, zglobovi, slezena ili oči), mogu se javiti dodatni simptomi, koji ovise o pogođenom organu.
Novorođenačka kandidijaza
Novorođenačka kandidijaza (Candidosis congenitalis generalisata) je poseban oblik infekcije kandidom, koja najvjerojatnije nastaje kao infekcija fetusa u maternici.
Kandidijaza je inače često stanje kod beba, posebno novorođenčadi, koje se često pojavljuje kao bijele mrlje na jeziku ili unutarnjoj strani obraza.
Iako općenito nije štetna, kandidijaza može uzrokovati nelagodu tijekom hranjenja.
Liječenje obično uključuje tekući antifungalni lijek koji propisuje liječnik.
Ponavljajuća (recidivirajuća) kandidijaza
Ponavljajuća (recidivirajuća) kandidijaza definira se kao četiri ili više dokazanih epizoda vulvovaginalne kandidijaze u razdoblju od 12 mjeseci, koje treba barem jednom potvrditi kulturom. Može se pojaviti kod oko 10 posto žena.
Razlog pojave može biti nekontrolirana uporaba antibiotika, loše kontrolirana osnovna bolest (npr. dijabetes mellitus), infekcija HIV-om ili drugi uzroci imunosupresije i hormonske promjene.
Ginekološkim pregledom treba isključiti i druge moguće uzroke (npr. dermatitis, herpes simplex virusnu infekciju itd.
Kod nekih pacijentica neće biti moguće pronaći prepoznatljivog čimbenika rizika ili okidač.
U slučaju postojanja rekurentne kandidijaze, nije uputno samoliječenje, nego isključivo liječenje kod odabranog ginekologa koji će ujedno pratiti stanje i povremeno uzeti vaginalni bris ili testirati odgovor na terapiju kako bi se utvrdilo je li kandida otporna na liječenje koje se koristi.
Kronične gljivične infekcije kože vulve mogu se pojaviti čak i s negativnim brisovima.
Liječenje muškog spolnog partnera. Liječenje muškog spolnog partnera žena s rekurentnom vaginalnom kandidijazom ne pokazuje nikakvu korist. Liječenje se preporučuje muškarcima samo kada i sami imaju simptome, po mogućnosti nakon što su uzeti brisevi i potvrđena je Candida albicans.
Savjetovanje. Pacijentice treba savjetovati o sljedećim čimbenicima rizika koji podupiru pojavu recidivirajuće kandidijaze, a čija modifikacija može pomoći u njezinu sprječavanju:
- učestalost terapije antibioticima
- (ne)pridržavanje terapije postojeće bolesti (npr. dijabetesa)
- korištenje lokalnih iritansa, npr. sapuni/gelovi za tuširanje/ispiranje
- postojeća imunosupresija (npr. liječenje HIV-a i dugotrajna primjena kortikosteroida)
- utjecaj endogenih ili egzogenih estrogena (npr. trudnoća, kombinirani kontraceptivi, hormonska nadomjesna terapija).
Je li kandidijaza spolno prenosiva bolest?
Kandidijaza nije spolno prenosiva bolest, jer je primarno uzrokovana prekomjernim rastom na tijelu već prisutne Candide.
Kandidijaza se pojavljuje u stanjima promijenjene ravnoteže kvasaca i dobrih bakterija u tijelu, odnosno zaštitnih laktobacila (zbog antibiotske terapije, dijabetesa, trudnoće, uzimanja kortikosteroidne terapije, stanja smanjena imuniteta), a može se dobiti i preko zahodske daske, mokrog ručnika, na bazenu itd.
Ravnoteža kvasaca može se promijeniti i kao rezultat spolne aktivnosti, ali spolni odnos ne uzrokuje infekciju.
Iako se Candida obično ne prenosi spolnim putem, ponekad se može prenijeti na partnera, a spolna aktivnost može izazvati infekciju trenjem ili promjenama pH vrijednosti.
U liječenje je poželjno uključiti i spolnog partnera.samo kada i sami imaju simptome, po mogućnosti nakon što su uzeti brisevi i potvrđena je Candida albicans.
Općenito, liječenje muškog spolnog partnera žena s rekurentnom vaginalnom kandidijazom ne pokazuje nikakvu korist.
Kada se obratiti liječniku
Neliječeni simptomi kandidijaze mogu se s vremenom pogoršati, stoga je najbolje posjetiti liječnika kod pojave bilo kakvih simptoma koji upućuju na infekciju, uključujući:
- svrbež
- bol
- osip
- oticanje.
Liječniku se svakako treba obratiti ako se radi o pojavi kandidijaze u trudnoći, ako je je kandidijaza otporna na liječenje ili se infekcija ponavlja, a uzrok nije poznat.
Dijagnostika kandidijaze
Dijagnostički postupak započinje uzimanjem anamnestičkih podataka o postojećim tegobama, bivšim i sadašnjim bolestima, lijekovima koji se uzimaju, učestalosti uporabe antibiotika, prehrani itd.
U ovisnosti na koju vrstu kandidijaze se sumnja, nadopunjuje se profil pitanja. Primjerice, ako liječnik posumnja na kožnu kandidijazu, može postaviti dodatna pitanja vezana uz njegu kože i stanja koja kožu izlažu prekomjernoj vlazi.
Kožnu i vaginalnu kandidijazu moguće je dijagnosticirati već jednostavnim fizikalnim pregledom.
Pregledom razmaza vaginalnog iscjetka liječnik pod svjetlosnim mikroskopom može potvrditi optičku dijagnozu gljivične infekcije.
Ako je mikroskopski nalaz na gljive negativan, obrisak rodnice šalje se na mikrobiološko ispitivanje (kultura obriska rodnice i nasađivanje na specijalne podloge).
Kultura je posebno korisna ako je u pitanju gljivična infekciju koja se vraća nakon liječenja. U tom slučaju, kultura može pomoći u utvrđivanju je li kvasac otporan na uobičajenu antifungalnu terapiju.
Prisutnost kandide može se dijagnosticirati pomoću testova. Ovisno o laboratoriju, može se provesti analiza stolice ili mokraće na gljivice, odnosno analiza sline ili krvi na antikandida protutijela.
U slučaju ponavljajućih infekcija i slabog odgovora na liječenje (kod oko 10 posto osoba), obradu treba proširiti laboratorijskim ispitivanjima krvi i mokraće, kako bi se dijagnosticirao osnovni poremećaj ili bolest koja dovodi do recidiva.
Ako liječnik posumnja na nedijagnosticiranu bolest koja povećava rizik od kandidijaze - poput dijabetesa, raka ili HIV-a - mogu biti potrebne dodatne pretrage.
Za dijagnozu kandidijaze jednjaka, potreban je specijalistički pristup i endoskopski pregled, tijekom kojeg liječnik uzima uzorak tkiva jednjaka za patofiziološku analizu (PHD).
Za dijagnosticiranje sistemske kandidijaze, liječnik će uzeti uzorak krvi za laboratorijsku provjeru na rast gljivica Candida ili drugih zaraznih uzročnika.
Načela laboratorijske dijagnostike kandidijaze
Načela laboratorijske dijagnostike kandidijaze svode se na nekoliko osnovnih tehnika:
- mikroskopski pregled uzorka
- izolacija gljiva iz uzorka (mikološka kultura).
Za izolaciju i identifikaciju gljiva iz bolesničkog materijala koristi se temperatura od 25 ºC i 37 ºC.
Uzorak za kultivaciju uzima se sterilnim brisom sa sluznice i kože zaraženih osoba i inkubira na specijalnim hranjivim podlogama (Sabouraudov glukozni agar uz dodatak antibotika, na 37 ºC tijekom 24 do 72 sata u aerobnim uvjetima ili kukuruzni i rižin agar) nekoliko dana (u prosjeku dva tjedna), dok se ne razviju kolonije (na izgled su glatke, sjajne, konveksne i bijele su boje).
Za dokaz genitalne kandidijaze koristi se obrisak rodnice u žena, odnosno glansa i prepucija u muškaraca.
U dijagnostici gljivičnih infekcija drugih lokalizacija pomaže obrisak usne šupljine, mokraće i stolice.
S obzirom na to da se kandida u malim količinama i normalno nalazi u ljudskom tijelu, njezin nalaz u mokraći, stolici i ispljuvku treba pomno interpretirati.
Plijesni se identificiraju pregledom makroskopskog izgleda kulture i mikroskopskog izgleda konidija i hifa.
Kod kvasnica se koriste metode neizravne mikološke dijagnostike radi detekcije antigena i antitijela imunoserološkim metodama (obično se koriste za dokazivanje sistemske kandidijaze).
Odličnom metodom dokaza gljivica pokazala se detekcija gljivične DNA molekularnim tehnikama. Jedna od njih je PCR metoda, koja je visoko osjetljiva i specifična, jer se pomoću nje mogu otkriti iznimno male količine gljivične DNK.
Liječenje kandidijaze
Najčešće infekcije Candidom, poput vaginalnih i kožnih infekcija, lokalizirane su i mogu se liječiti antifungalnim lijekovima (antimikotici - lijekovi koji uništavaju gljive ili sprječavaju njihov rast).
U načelu, kandidijaza ne prolazi sama od sebe, a neliječena infekcija nosi rizik od sistemske infekcije kada mogu biti zahvaćeni i drugi organi.
Antifungalni lijekovi dolaze u različitim oblicima:
- topikalni oblici (kreme, pastile, vodice za ispiranje usta)
- tablete
- intravenske otopine (uzimaju se kroz venu).
Vrsta, doza i trajanje antifungalnog liječenja ovise o vrsti i težini infekcije te osnovnim zdravstvenim stanjima.
Blaži oblici kandidijaze mogu se liječiti u kućnim uvjetima lokalnim antimikotikom dostupnim bez recepta u ljekarni.
Liječenje kandidijaze varira ovisno o zahvaćenom području:
Liječenje kandidijaze mokraćnog sustava
Liječenje kandida infekcije mokraćnog sustava preporučuje se samo osobama koje imaju simptome.
U mnogim slučajevima može se koristiti antifungalni lijek flukonazol..
Ako osoba ima postavljen kateter, treba ga ukloniti.
Liječenje vaginalne kandidijaze
Za liječenje vaginalne gljivične infekcije primjenjuju se antimikotici u obliku vaginalnih tableta, krema ili masti (klotrimazol, mikonazol, nistatin, tiokonazol). Terapija traje oko tjedan dana.
Ako se infekcija ponavlja, nužno je liječenje antimikoticima u obliku tableta ili kapsula (flukonazol).
U slučaju miješane infekcije gljivama i bakterijama, liječenje se može provesti kombinacijom antibiotika i antimikotika.
Žene koje već imaju iskustvo s ovom infekcijom i sigurne su da je riječ upravo o njoj, i ako nisu u rizičnoj skupini za spolne bolesti, mogu provesti samoliječenje lokalnim antimikotikom koji se može kupiti u ljekarni.
Ako se tijekom sedmodnevne terapije tegobe ipak ne saniraju, potrebno je javiti se svom ginekologu, jer je možda posrijedi miješana infekcija koja ne reagira samo na liječenje antimikotikom ili neko drugo stanje koje simptomima imitira gljivičnu infekciju.
U slučaju miješane infekcije gljivama i bakterijama, liječenje se može provesti kombinacijom antibiotika i antimikotika.
U slučaju infekcija u trudnoći, liječnički pregled je neophodan. Lokalno liječenje provodi se s velikim oprezom i dulje traje nego kod žena koje nisu trudne, a i kontrole su češće.
Na tržištu postoje i lokalni pripravci na bazi ulja australskog čajevca i gel na bazi aloe vere, koji se mogu koristiti dulje vrijeme. Kako djeluju u smislu regulacije pH vrijednosti na vaginalnoj sluznici, mogu se koristiti i preventivno.
Iako nije spolno prenosiva bolest, preporučuje se ne održavati spolne odnose sve dok traju terapija i simptomi.
Seksualni partneri obično ne trebaju liječenje.
Liječenje kandidijaze probavnog sustava
Za liječenje oralne kandidijaze primjenjuju se
- posebni antifungalni gelovi ili suspenzije koji se mogu koristiti lokalno na sluznici poput nistatina i klotrimazola
- oralni antiseptici, ili
- oralni antimikotici poput fukonazola za teže slučajeve.
Candida ezofagitis liječi se oralnim antifungalnim lijekom poput flukonazola.

Liječenje kožne kandidijaze (dermatomikoza)
Liječenje dermatomikoza ovisi o nekoliko čimbenika, a najvažniji su:
- lokalizacija promjena (gola koža, vlasište, nokti, područja koja se međusobno taru)
- upalni stadij (akutni, kronični)
- dubina prodora uzročnika (površinska ili duboka upala).
Zahvaćeno područje mora se održavati čistim i suhim te zaštićeno od trenja.
Terapija može biti lokalna (antifungalne kreme, masti, otopine, sprejevi ili posipi čija primjena ovisi o lokalizaciji) i sistemska, a provodi se primjenom antimikotika.

Liječenje sistemne kandidijaze
Sistemska kandidijaza liječi se oralnom ili intravenskom dozom antifungalnih lijekova poput flukonazola.
Osobama s vrlo niskim brojem bijelih krvnih stanica može biti potreban alternativni intravenski antifungalni lijek, poput kaspofungina ili mikafungina.

Liječenje ponavljajuće (recidivirajuće) kandidijaze
Liječenje recidivirajuće kandiidijaze podrazumijeva dugotrajnu primjenu antimikotika, uz promjenu životnih navika, prvenstveno prehrambenih.
Prevencija kandidijaze
Neke od općih mjera za sprječavanje kandidijaze uključuju:
- održavanjem dobre higijene
- upravljanjem stresom
- smanjenje unosa rafiniranih ugljikohidrata i šećera te alkohola
- liječenje trenutačnih zdravstvenih stanja
- razgovorom s liječnikom o lijekovima koji se uzimaju
- uzimati terapiju strogo prema preporuci liječnika
- korištenje antibiotika samo kada je propisano i kada je to potrebno
- pojačan unos dobrih bakterija tijekom liječenja antibioticima.

Prevencija kandidijaze mokraćnog sustava
Sprječavanje kandidijaze mokraćnog sustava uključuje smanjenje čimbenika rizika:
- održavanje dobre higijene - održavanje genitalnog područja suhim, nošenje prozračnog pamučnog donjeg rublja i brzo uklanjanje
- pravovremeno uklanjanje ili redovita zamjena mokraćnih katetera
- liječenje temeljnih stanja poput dijabetesa
- održavanje redovitog unosa dobrih bakterija.
Za pacijente visokog rizika, poput onih s oslabljenim imunosnim sustavom ili teškim, upornim infekcijama, liječnik može razmotriti antifungalnu profilaksu.
Prevencija vaginalne kandidijaze
S ciljem prevencije vaginalne kandidijaze uputno je:
- izbjegavati nošenje uske odjeće i sintetičkog donjeg rublja te stalno vlaženje genitalnog područja
- nositi pamučno donje rublje i široku odjeću
- pojačati unos dobrih bakterija tijekom liječenja antibioticima (dobro i za probavni sustav) te smanjiti unos ugljikohidrata i alkohola
- ne koristiti dezodorirajuća i parfimirana sredstva i ne prati spolovilo neprilagođenim sredstvima
- upotrebljavati pomoćna sredstva koja djeluju u smislu regulacije pH vrijednosti na vaginalnoj sluznici
- uzimati terapiju strogo prema preporuci liječnika.
Prevencija kandidijaze probavnog sustava
U sprječavanju ili smanjenju rizika od oralne kandidijaze mogu pomoći:
- dobra oralna higijena
- pravilno čišćenje proteze
- liječenje i kontrola dijabetesa, kserostomije, Sjogrenovog sindroma i sl.
- izbjegavanje pušenja
- pravilna upotreba steroidnih inhalatora itd.
Prevencija kožne kandidijaze
S ciljem prevencije kožne infekcije kandidom, potrebno je održavati pravilnu higijenu, posebno na vlažnim područjima i djelovati na čimbenike koji pogoduju umnožavanju gljiva općenito, kao što su prekomjerno znojenje, trljanje kože o kožu (pregibi).
Potrebno je pridržavati se i općih higijenskih mjera:
- poslije plivanja, kupanja ili tuširanja pažljivo osušiti kožu i redovito mijenjati ručnik
- izbjegavati sintetičku odjeću, jer ne dopušta koži disati, a i pogoduje znojenju
- u slučaju pojačanog znojenja nogu, mijenjati čarape (pamučne) i nekoliko puta dnevno
- birati obuću koja dopušta cirkulaciju zraka i izbjegavati tijesnu obuću; sportsku i zimsku obuću redovito čistiti i zračiti
- ne posuđivati obuću ili čarape (nekome ili od nekoga), ne hodati bos na bazenima, ne koristiti tuđe ručnike
- održavati čistim i suhim podove prostorija koje dijeli mnogo ljudi (npr. teretane i sportski objekti)
- redovito čistiti i sušiti opremu i odjeću.
Prevencija sistemske kandidijaze
Kako bi se spriječila sistemska kandidijaza, za osobe s oslabljenim imunosnim sustavom mogu biti potrebni redoviti liječnički pregledi i profilaktička primjena antifungalnih lijekova.
Kandidijaza - prehrambeni savjeti
Problem infekcije kandidom može se riješiti radikalnim promjenama načina prehrane uz nekoliko mjeseci stroge dijete, poznatije kao antikandida program.
U slučaju pojave kandidjaze, neovisno o njezinoj lokalizaciji, potrebno je znati:
- što izbjegavati
- što je poželjno
- koje dodatke prehrani koristiti.
Koju hranu treba izbjegavati kod kandidijaze
U slučaju pojave kandidijaze uputno je izbjegavati:
- šećer jer se gljivice hrane šećerom, razlažući ga do ugljičnog dioksida i vode
- namirnice koje sadrže gljivice i plijesni - kao što su kruh, kolači, keksi i drugi rafinirani ugljikohidrati, industrijski voćni sokovi, umak od rajčice (osim domaćeg)
- hranu koja sadrži ocat, ukiseljeno povrće, dimljenu hranu, alkohol, fermentiranu hranu, sušeno meso i voće, gljive, pistacije i kikiriki.

Koju hranu je poželjno unositi
U obrani od gljivica pa tako i kanidide poželjno je unositi sljedeće namirnice:
- cjelovite žitarice (smeđa riža, proso, ječam)
- svježe povrće, posebno zeleno, pripremljeno na pari (obiluje klorofilom koji pročišćava)
- morske biljke, raženi kruh, kukuruzne kokice, tortilje, tofu, miso, obični jogurt, krto meso, svježa riba, meso prirodno hranjene peradi i jaja prirodno hranjenih kokoši
- novija istraživanja pokazuju kako i prirodno čisto maslinovo ulje, u malim količinama, suzbija neprirodno razmnožavanje gljivica
- češnjak, sirov ili kratko prokuhan (crijeva).

Dodaci prehrani koji mogu pomoći kod kandidijaze
Katkad promjena načina prehrane nije dovoljna u obrani od gljivica, pa se u suzbijanju gljivične infekcije mogu koristiti i neki dodaci prehrani:
- Lactobacili – dobre bakterije koje u prirodnim uvjetima naseljavaju crijeva i rodnicu. Stvaraju mliječnu kiselinu koja snižava pH sredine u kojoj se nalaze i utječu na jačanje prve obrambene linije u razvoju različitih infekcija. Prirodni izvor su različiti jogurti, a postoje i brojni suplementi koji sadrže ove bakterije (u obliku tableta, kapsula, praha i napitaka).
- Sredstva protiv gljivica - osim lijekova, od pomoći mogu biti ekstrakt limunovih sjemenki, češnjak, kaprilna kiselina i berberin, koje možete potražiti u nekoj od trgovina zdrave hrane. Ne resorbiraju se u krv, pa se mogu uzimati i za vrijeme trudnoće i dojenja.
- Homeopatski pripravci - koji potpomažu uspostaviti zdravu ravnotežu gljivica u organizmu.
- Multivitaminski preparati - vitamin C, vitamini B kompleksa, cink, magnezij, elementi u tragovima i esencijalne masne kiseline pospješuju obrambenu sposobnost i sprječavaju povrat gljivične infekcije.
Što mogu očekivati ako imam kandidijazu?
Liječenje kandidijaze izuzetno je učinkovito.
Simptomi su neugodni, ali bi trebali početi nestajati nakon početka liječenja. Infekcije obično potpuno nestanu između dva dana i dva tjedna, ovisno o vrsti i težini.
Ako se ne liječe, simptomi kandidijaze mogu uzrokovati iritaciju i nelagodu te se s vremenom mogu pogoršati.
Ponekad se kandidijaza vrati nakon liječenja, stoga je najbolje surađivati sa svojim liječnikom po pitanju plana liječenja.
Izvor fotografija: Adobe Stock


